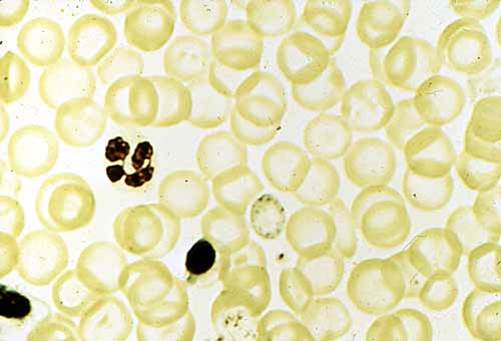
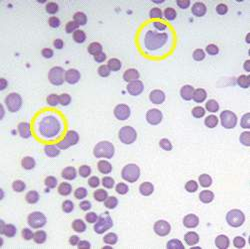

【学习目标】
掌握 铅、汞、砷、镉等常见毒物的毒作用特点及其特征性临床表现;
重要的实验室检查指标,诊断依据、解毒治疗的特效药物及
预防的特殊措施。
熟悉 铅、汞等常见毒物的理化性质、主要接触机会和毒理;
了解 镉、砷、锰等常见毒物的理化性质、主要接触机会和毒理、
诊断处理原则及预防措施。
第三章 生产性毒物与职业中毒 第二节 金属和类金属中毒 电子教材
第三章 生产性毒物与职业中毒 第二节 金属和类金属中毒 授课视频
1. 概述
2. 铅中毒
注:职业性铅中毒的诊断标准已修订,自2025年5月1日起,实施《职业性铅及其无机化合物中毒诊断标准(GBZ 37—2024)》。
铅中毒知识拓展:古罗马人接触铅的过程_探索·发现_视频_央视网
3. 汞中毒
注:职业性汞中毒的诊断标准已修订,自2025年5月1日起,实施《职业性汞中毒诊断标准(GBZ 897—2024)》。
4. 其他金属与类金属(锰、砷、镉中毒)
以下为参考资料:
第三章 生产性毒物与职业中毒 第二节 金属和类金属中毒 课件
工作场所有害因素职业接触限值:化学因素
职业病诊断通则
职业性铅及其无机化合物中毒的诊断(2024)
职业性汞中毒诊断标准(2024)
职业性慢性锰中毒诊断标准
职业性砷中毒的诊断
职业性镉中毒的诊断
请观看中视网视频:铅 穿越时空的幽灵(上)和铅 穿越时空的幽灵(下)。
央视网视频 > 探索·发现 > 远离毒素(七):铅 穿越时空的幽灵(上)
http://tv.cntv.cn/video/C14092/6630bbda4b4e45ac68a829a8fec9b837
央视网视频 > 远离毒素 > 远离毒素(八):铅 穿越时空的幽灵(下)
http://tv.cntv.cn/video/C15773/c9cab68f597946852d0a3faefd7cec5d
金属和类金属及其合金、化合物广泛应用工业,尤其在建筑业、汽车、航空航天、电子和其他制造工业以及在油漆、涂料和催化剂生产上都大量使用。各种金属都是通过矿山开采、冶炼、精炼和加工后成为其他工业用的金属原料。因此,从矿山开采、冶炼到加工成金属以及应用这些金属时,都会对车间和工作场所造成污染,给工人健康造成潜在的危害。了解有害金属和类金属的理化特性、接触机会、毒性和毒理作用及可能引起的中毒,在职业医学中具有特殊重要性。
和其他毒物中毒一样,每一种金属因其毒性和靶器官不同而出现不同的临床表现。很多金属具有靶器官性,即在有选择性的器官或组织中蓄积并发挥生物学效应,并因此引起慢性毒性作用。金属也可与有机物结合,改变其物理特性和毒性,如氰化物和羰基化物毒性很大。急性金属中毒多由食入含金属化合物食品或吸入高浓度金属烟雾或金属气化物所致。在现代工业操作中,这种类型的接触比较少见,常常是由于意外的化学反应、事故或在密闭空间燃烧或焊接造成。低剂量长时间接触金属和类金属引起的慢性毒性作用是目前金属中毒的重点。
了解金属中毒表现,结合职业史可帮助诊断。大多数金属通过代谢可在血和尿中检出从而帮助确立诊断。随着科学技术,特别是医学检测技术的进展,对以前认为是安全的接触剂量可能提出质疑。医学监测和生物学检测对于确定安全接触剂量和诊断是十分重要的。金属毒物在体内代谢过程中,一般主要通过和体内巯基及其他配基形成稳定复合物而发挥生物学作用,正是这种特性构成了应用络合剂疗法治疗金属中毒的基础。治疗金属中毒常用的络合剂有两种,即氨羧络合剂和巯基络合剂。氨羧络合剂中的氨基多羧酸能与多种金属离子络合成无毒的金属络合物并排出体外,如依地酸二钠钙、促排灵。巯基络合剂的碳链上带有巯基,可和金属结合,保护人体的巯基酶系统,免受金属的抑制作用,同时可解救已被抑制的巯基酶,使其活性恢复。如二巯基丙醇、二巯基丙磺酸钠、二巯基丁二酸钠、青霉胺等。
(一)铅
【理化特性】铅(lead,Pb)为灰白色重金属。原子量207.20,比重11.3,熔点327℃,沸点1620℃。金属铅质地较软,延展性较大,常温下即可轧铅皮、铅箔。当加热至400℃~500℃时,即有大量铅蒸气逸出,在空气中氧化成氧化亚铅(Pb2O),并凝集为铅烟。随着熔铅温度升高,还可逐步生成氧化铅(密陀僧,PbO)、三氧化二铅(黄丹,Pb2O3)、四氧化三铅(红丹,Pb3O4)。除了铅的氧化物以外,常用的铅化合物还有碱式碳酸铅[PbCO3•2Pb(OH)2]、铬酸铅(PbCrO4)、醋酸铅[Pb(CH3COO)2•3H2O]、砷酸铅[Pb3(AsO4)]、硅酸铅(PbSiO3)等。金属铅不溶于水,但溶于稀盐酸、碳酸和有机酸,铅尘遇湿和CO2变为PbCO3。铅的化合物多为粉末状,大多不溶于水,但可溶于酸。
【接触机会】
1.铅矿开采及冶炼:工业开采的铅矿主要为方铅矿(硫化铅)、碳酸铅矿(白铅矿)及硫酸铅矿。开矿时,呼吸和消化道接触均为重要途径。在铅冶炼时,混料、烧结、还原和精炼过程中均可接触。在冶炼锌、锡、锑等金属和制造铅合金时,亦存在铅危害。


铅的冶炼 铅的冶炼
2.熔铅作业:制造铅丝、铅皮、铅箔、铅管、铅槽、铅丸等,旧印刷业的铸版、铸字,制造电缆,焊接用的焊锡,废铅回收等,均可接触铅烟、铅尘或铅蒸气。
3.铅化合物:铅氧化物常用于制造蓄电池、玻璃、搪瓷、景泰蓝、铅丹、铅白、油漆、颜料、釉料、防锈剂、橡胶硫化促进剂等。铅的其他化合物如醋酸铅用于制药、化工工业,铬酸铅用于油漆、颜料、搪瓷等工业,碱式硫酸铅、碱式亚磷酸铅、硬脂酸铅等用作塑料稳定剂,砷酸铅用作杀虫剂、除草剂等。
【毒理】
1.吸收:铅化合物可通过呼吸道和消化道吸收。生产过程中,铅及其化合物主要以粉尘、烟和蒸气的形式存在,所以呼吸道是主要吸入途径,其次是消化道。铅及其无机铅化合物不能通过完整皮肤,但四乙基铅可通过皮肤和黏膜吸收。铅经呼吸道吸收较为迅速,吸入的氧化铅烟约有40%吸收入血循环,其余由呼吸道排出。铅尘的吸收取决于颗粒大小和溶解度。消化道摄入的铅化合物约有5%~10%通过胃肠道吸收,空腹时可高达45%,缺铁、缺钙及高脂饮食可增加胃肠道对铅的吸收。儿童经过呼吸道和消化道对铅的吸收率明显高于成人。
2.分布:进入血液的铅90%与红细胞结合,其余在血浆中。血浆中的铅一部分是活性较大的可溶性铅,主要为磷酸氢铅(PbHPO4)和甘油磷酸铅,另一部分是血浆蛋白结合铅。血循环中的铅早期主要分布于肝、肾、脑、皮肤和骨骼肌中,数周后,由软组织转移到骨,并以难溶的磷酸铅[Pb3(PO4)2]形式沉积下来。铅在骨内先进入长骨小梁部,然后逐渐分布于皮质。人体内90%~95%的铅储存于骨内,一部分比较稳定,半减期约为20年,一部分具有代谢活性,可迅速向血液和软组织转移,半减期为19天。

铅的分布与中毒症状发作的关系
3.代谢:铅在体内的代谢与钙相似,凡能影响钙在体内贮存和排出的因素,均可影响到铅的代谢。当缺钙或因感染、饮酒、外伤、服用酸性药物等改变体内酸碱平衡时,以及骨疾病(如骨质疏松、骨折),可导致骨内储存的磷酸铅转化为溶解度增大100倍的磷酸氢铅而进入血液,引起铅中毒症状发作或使其症状加重。骨铅与血液和软组织中的铅保持着动态平衡。
4.排泄:体内的铅主要通过肾脏随尿排出,尿中排出量可代表铅吸收状况。少部分铅可随粪便、唾液、汗液、乳汁、月经、脱落的皮屑等排出。乳汁内的铅可影响婴儿,血铅也可通过胎盘进入胎儿体内而影响到子代。
5.毒作用机理:铅中毒机理在某些方面尚有待研究。铅作用于全身各系统和器官,主要累及血液及造血系统、神经系统、消化系统、血管及肾脏等。到目前为止,在铅中毒机制研究中,铅对卟啉代谢紊乱和血红素合成影响的研究最为深入,并认为出现卟啉代谢紊乱是铅中毒重要和较早的变化之一。铅对卟啉代谢和血红素合成的影响见图3-1。

卟啉代谢和血红素合成是在一系列酶促作用下发生的。在这个过程中,目前比较清楚的是铅抑制δ-氨基-γ-酮戊酸脱水酶(ALAD)和血红素合成酶。ALAD受抑制后,δ-氨基-γ-酮戊酸(ALA)形成胆色素原受阻,使血ALA增加并由尿排出。血红素合成酶受抑制后,二价铁离子不能和原卟啉Ⅸ结合,使血红素合成障碍,同时红细胞游离原卟啉(FEP)增加,使体内的Zn离子被络合于原卟啉Ⅸ,形成锌原卟啉(ZPP)。铅还可抑制δ-氨基-γ-酮戊酸合成酶(ALAS),但由于ALA合成酶受血红素反馈调节,铅对血红素合成酶的抑制又间接促进ALA合成酶的生成。
此外,铅对红细胞,特别是骨髓中幼稚红细胞具有较强的毒作用,形成点彩细胞增加。在铅作用下,骨髓幼稚红细胞可发生超微结构的改变,如核膜变薄,胞浆异常,高尔基体及线粒体肿胀,细胞成熟障碍等。线粒体中存在大量含铁胶粒,散在于胞浆,是铁失利用的结果。铅在细胞内可与蛋白质的巯基结合,干扰多种细胞酶类活性,例如铅可抑制细胞膜三磷酸腺苷酶,导致细胞内大量钾离子丧失,使红细胞表面物理特性发生改变,寿命缩短,脆性增加,导致溶血。
目前,铅对神经系统的损害日益受到关注。除了对神经系统的直接毒作用外,还由于血液中增多的ALA可通过血脑屏障进入脑组织,因其与γ-氨基丁酸(GABA)化学结构相似,可与GABA竞争突触后膜上的GABA受体,产生竞争性抑制作用。GABA位于中枢神经的突触前及突触后的线粒体中,因GABA的抑制而干扰神经系统功能,出现意识、行为及神经效应等改变。铅还对脑内儿茶酚胺代谢产生影响,使脑内和尿中高香草酸(HVA)和香草扁桃酸(VMA)显著增高,最终导致中毒性脑病和周围神经病。铅还可损害周围神经细胞内线粒体和微粒体,使神经细胞膜改变和脱髓鞘,表现为神经传导速度减慢。
铅可抑制肠壁碱性磷酸酶和ATP酶的活性,使肠壁和小动脉平滑肌痉挛收缩,肠道缺血引起腹绞痛。
铅可影响肾小管上皮线粒体功能,抑制ATP酶活性,引起肾小管功能障碍甚至损伤,造成肾小管重吸收功能降低,同时还影响肾小球滤过率。
【临床表现】 经口摄入大量铅化合物可致急性铅中毒,多表现为胃肠道症状,如恶心、呕吐、腹绞痛,少数出现中毒性脑病。工业生产中急性中毒已极罕见。职业性铅中毒基本上为慢性中毒,早期表现为乏力、关节肌肉酸痛、胃肠道症状等。随着接触增加,病情进展可出现以下几个方面的表现:
1.神经系统:主要表现为类神经征、周围神经病,严重者出现中毒性脑病。类神经征是铅中毒早期和常见症状,表现为头昏、头痛、乏力、失眠、多梦、记忆力减退等,属功能性症状。周围神经病分为感觉型、运动型和混合型。感觉型表现为肢端麻木,四肢末端呈手套、袜套样感觉障碍。运动型表现为握力减退,进一步发展为伸肌无力和麻痹,甚至出现“腕下垂”或“足下垂”。中毒性脑病表现为头痛、恶心、呕吐、高热、烦躁、抽搐、嗜睡、精神障碍,昏迷等症状,在职业性中毒中已极为少见。


腕下垂 腕下垂
2.消化系统:表现为食欲不振、恶心、隐性腹痛、腹胀、腹泻或便秘。重者可出现腹绞痛,多为突然发作,部位常在脐周,发作时患者面色苍白、烦躁、冷汗、体位卷曲,一般止痛药不易缓解,发作可持续数分钟以上。检查腹部常平坦柔软,轻度压痛但无固定点,肠鸣减弱,常伴有暂时性血压升高和眼底动脉痉挛。
3.血液及造血系统:可有轻度贫血,多呈低色素正常细胞型贫血;卟啉代谢障碍,点彩红细胞、网织红细胞、碱粒红细胞增多等。

点彩红细胞 点彩红细胞

网织红细胞 网织红细胞
4.其他:口腔卫生不好者,在齿龈与牙齿交界边缘上可出现由硫化铅颗粒沉淀形成的暗蓝色线,即铅线(lead line,blue line)。部分患者肾脏受到损害,表现为近曲小管损伤引起的Fanconi综合征,伴有氨基酸尿、糖尿和磷酸盐尿;少数较重患者可出现蛋白尿,尿中红细胞、管型及肾功能减退。此外,铅可使男工精子数目减少、活动力减弱和畸形率增加;还可导致女性月经失调、流产、早产、不育等。

铅线
【诊断】 我国现行《职业性铅及其无机化合物中毒诊断标准》(GBZ37-2024),详见参考资料。
【处理原则】
1.观察对象:可继续原工作,3~6个月复查一次或进行驱铅试验明确是否为轻度铅中毒。
2.轻度、中度中毒:治愈后可恢复原工作,不必调离铅作业
3.重度中毒:必须调离铅作业,并根据病情给予治疗和休息。如需劳动能力鉴定者按GB/T16180处理。
4.治疗方法 包括:①驱铅疗法:常用金属络合剂驱铅,一般3~4日为一疗程,间隔3~4日,根据病情使用3~5个疗程。首选依地酸二钠钙(CaNa2-EDTA),每日1.0g静脉注射或加于25%葡萄糖液静脉滴注。CaNa2-EDTA可与体内钙、锌等形成稳定的络合物而排出,可能导致血钙降低或其他元素排出过多。故长期用药可出现“过络综合征”,患者自觉疲劳、乏力、食欲减退等,应注意观察。二巯基丁二酸钠(Na-DMS)每日1.0g,用生理盐水或5%葡萄糖液配成5%~10%浓度静脉注射。二巯基丁二酸胶囊(DMSA)副作用小,可口服,剂量为0.5g,每日三次。②对症疗法:根据病情给予支持疗法,如适当休息、合理营养等;如有类神经征者给以镇静剂,腹绞痛发作时可静脉注射葡萄糖酸钙或皮下注射阿托品。
【预防】 降低生产环境空气中铅浓度,使之达到卫生标准是预防的关键;同时应加强个人防护。
1.降低铅浓度:
(1)用无毒或低毒物代替铅:如用锌钡白、钛钡白代替铅白制造油漆,用铁红代替铅丹制造防锈漆,用激光或电脑排版代替铅字排版等;
(2)加强工艺改革:使生产过程机械化、自动化、密闭化。如铅熔炼用机械浇铸代替手工操作,蓄电池制造采用铸造机、涂膏机、切边机等,以减少铅尘飞扬;
(3)加强通风:如熔铅锅、铸字机、修版机等均可设置吸尘排气罩,抽出烟尘需净化后再排出;
(4)控制熔铅温度,减少铅蒸气逸出。我国车间空气中铅的最高容许浓度为:铅烟0.03mg/m3;铅尘0.05mg/m3。短时间接触容许浓度为:铅烟0.09mg/m3;铅尘0.15mg/m3。
2.加强个人防护和卫生操作制度:铅作业工人应穿工作服,戴滤过式防尘、防烟口罩。严禁在车间内吸烟、进食;饭前洗手,下班后淋浴。坚持车间内湿式清扫制度,定期监测车间空气中铅浓度和设备检修。定期对工人进行体检,有铅吸收的工人应早期进行驱铅治疗。妊娠及哺乳期女工应暂时调离铅作业。
3.职业禁忌证:贫血、神经系统器质性疾患、肝肾疾患、心血管器质性疾患。
(二)汞
【理化特性】
汞(mercury,Hg)俗称水银,为银白色液态金属,原子量200.59,比重13.6,熔点-38.9℃,沸点356.6℃。汞在常温下即能蒸发,气温愈高蒸发愈快,空气流动时蒸发更多;汞蒸气比重6.9。汞表面张力大、粘度小,易流动,在生产和使用过程中流散或溅落后即形成很多小汞珠,且可被泥土、地面缝隙、衣物等吸附,增加蒸发表面积并成为作业场所的二次污染源。汞不溶于水和有机溶剂,可溶于热硫酸、硝酸和类脂质。汞可与金银等金属生成汞合金(汞齐)。
【接触机会】
汞矿开采与冶炼,尤其是土法火式炼汞,除了职业接触外,还严重污染空气、土壤和水源。电工器材、仪器仪表制造和维修,如温度计、气压表、血压计、石英灯、荧光灯等。用汞作阴极电解食盐生产烧碱和氯气,塑料、染料工业用汞作催化剂。生产含汞药物及试剂,用于鞣革、印染、防腐、涂料等;用汞齐法提取金银等贵金属,用金汞齐镀金及镏金;口腔科用银汞齐填补龋齿;军工生产中,用雷汞制造雷管做起爆剂;在原子能工业中用汞作钚反应堆冷却剂等。

汞的冶炼
【毒理】
1.吸收:金属汞主要以蒸气形式经呼吸道进入体内。由于汞蒸气具有脂溶性,可迅速弥散,透过肺泡壁被吸收,吸收率可达70%以上;空气中汞浓度增高时,吸收率也增加。金属汞很难经消化道吸收,但汞盐及有机汞化合物易被消化道吸收。
2.分布及代谢:汞及其化合物进入机体后,最初分布于红细胞及血浆中,以后到达全身很多组织。最初集中在肝,随后转移至肾脏,主要分布在肾皮质,以近曲小管上皮组织内含量最多。汞在体内可诱发生成金属硫蛋白(metallothionein,MT),这是一种低分子富含巯基的蛋白质,主要蓄积在肾脏,对汞在体内的解毒和蓄积以及保护肾脏起一定作用。汞可通过血脑屏障进入脑组织,并在脑中长期蓄积。汞也易通过胎盘进入胎儿体内,影响胎儿发育。
3.排泄:汞主要经肾脏随尿排出,在未产生肾损害时,尿汞的排出量约占总排出量的70%;但尿汞的排出很不规则,且较为缓慢,停止接触后十多年,尿汞仍可超过正常值。少量汞可随粪便、呼出气、乳汁、唾液、汗液、毛发等排出。汞在人体内半减期约60天。
4.毒作用机理:汞中毒的机制尚不完全清楚。汞进入体内后,在血液内通过过氧化氢酶氧化为二价汞离子(Hg2+)。Hg2+与蛋白质的巯基(-SH)具有特殊亲和力,而巯基是细胞代谢过程中许多重要酶的活性部分,当汞与这些酶的巯基结合后,可干扰其活性甚至使其失活,如汞离子与GSH结合后形成不可逆复合物而损害其抗氧化功能;与细胞膜表面上酶的巯基结合,可改变酶的结构和功能。汞与体内蛋白结合后可由半抗原成为抗原,引起变态反应,出现肾病综合征,高浓度的汞还可直接引起肾小球免疫损伤。
汞与巯基结合并不能完全解释汞毒性作用的特点。汞毒性作用的确切机制仍有待进一步研究。
【临床表现】
1.急性中毒:短时间吸入高浓度汞蒸气或摄入可溶性汞盐可致急性中毒,多由于在密闭空间内工作或意外事故造成。一般起病急,有发热、咳嗽、呼吸困难、口腔炎和胃肠道症状,继之可发生化学性肺炎伴有发绀、气促、肺水肿等。急性汞中毒常出现皮疹,多数呈现泛发性红班、丘疹或斑丘疹,可融合成片。肾损伤表现为开始时多尿,继之出现蛋白尿、少尿及肾衰。急性期恢复后可出现类似慢性中毒的神经系统症状。口服汞盐可引起胃肠道症状,恶心、呕吐、腹泻和腹痛,并可引起肾脏和神经损害。
2.慢性中毒:慢性汞中毒较常见,其典型表现为易兴奋症、震颤和口腔炎。
(1)神经表现。初期表现为类神经征,如头昏、头痛、健忘、失眠、多梦等,部分病例可有心悸、多汗等自主神经系统紊乱现象,病情进一步发展则会性格改变,如急躁、易怒、胆怯、害羞、多疑等。震颤是神经毒性的早期症状,开始时表现为手指、舌尖、眼睑的细小震颤,多在休息时发生;进一步发展成意向性粗大震颤,也可伴有头部震颤和运动失调。震颤特点为意向性,即震颤开始于动作时,在动作过程中加重,动作完成后停止,被别人注意、紧张或愈加以控制时,震颤程度常更明显加重。震颤、步态失调、动作迟缓等症候群,类似帕金森病,后期可出现幻觉和痴呆。

有手震颤体征的慢性汞中毒患者的手迹
(2)口腔-牙龈炎 早期多有流涎、糜烂、溃疡、牙龈肿胀、酸痛、易出血;继而可发展为牙龈萎缩、牙齿松动,甚至脱落;口腔卫生不良者,可在龈缘出现蓝黑色汞线。
(3)肾脏损害 少数患者可有肾脏损害。早期因肾小管重吸收功能障碍可表现为NAG和β-MG和视黄醇结合蛋白(RBP)含量增高;随着病情加重,肾小球的通透性改变,尿中出现高分子蛋白、管型尿甚至血尿,可见肿。
(4)其他 胃肠功能紊乱、脱发、皮炎、免疫功能障碍,生殖功能异常,如月经紊乱、不育、异常生育等。
实验室检查:尿汞反映近期汞接触水平,急性汞中毒时,尿汞往往明显高于生物接触限值(我国正常人尿汞正常值2.25mmol/mol肌酐,4mg/g肌酐);长期从事汞作业的劳动者,尿汞往往高于其生物接触限值(20mmol/mol肌酐,35mg/g肌酐)。尿汞正常者经驱汞试验(用5%二巯基丙磺酸钠5ml一次肌注,留24h尿,再测尿汞)尿汞大于45mg/天,亦提示有过量汞吸收。尿汞测定多推荐用冷原子吸收光谱法。
【诊断】 具体诊断标准参见《职业性汞中毒诊断标准》(GBZ89-2024),详见参考资料部分。
【处理原则】
1.治疗原则:①急性中毒治疗原则 迅速脱离现场,脱去被污染的衣服,静卧保暖;特别要注意的是口服汞盐患者不应洗胃,需尽快服蛋清、牛奶或豆浆等,以使汞与蛋白质结合,保护被腐蚀的胃壁。也可用0.2%~0.5%的活性炭洗胃,同时用50%硫酸镁导泻。驱汞治疗主要应用巯基络合剂,常用二巯基丙磺酸钠(Na-DMPS)和二巯基丁二酸钠。急性中毒时,可用二巯基丙磺酸钠125-250mg,肌内注射,每4~6小时一次,2天后125mg,每日一次,疗程视病情而定;②慢性中毒治疗原则 应调离汞作业及其他有害作业;驱汞治疗,用二巯基丙磺酸钠125~250mg,肌内注射,每日一次,连续3天,停4天为一疗程,一般用药3~4疗程。或用二巯基丁二酸钠、二巯丁二钠治疗;对症治疗原则与内科相同。
2.其他处理
(1)观察对象 根据具体情况可进行药物驱汞治疗,
(2)急性和慢性轻度中毒 治愈后仍可从事正常工作。
(3)中度及重度中毒治愈后,不宜再从事接触汞及其他有害物质的作业,如需劳动能力鉴定,按GB/T16180处理。
【预防】
1.改革工艺及生产设备,控制工作场所空气汞浓度:用无毒原料代替汞,如电解食盐采用离子膜电解代替汞作阴极,硅整流器代替汞整流器,电子仪表、气动仪表代替汞仪表。实现生产过程自动化、密闭化。加强通风排毒,如从事汞的灌注、分装应在通风柜内进行,操作台设置板孔下吸风或旁侧吸风。为防止汞污染和沉积,敞开容器的汞液面可用甘油或5%硫化钠液等覆盖,防止汞蒸气的蒸发;车间地面、墙壁、天花板、操作台宜用不吸附汞的光滑材料,操作台和地面应有一定倾斜度,以便清扫与冲洗,低处应有贮水的汞吸收槽;可用1g/m3的碘加酒精点燃熏蒸,使空气中的汞生成不易挥发的碘化汞。对排出的含汞蒸气,应用碘化或氯化活性炭吸附净化。
2.加强个人防护,建立卫生操作制度:接汞作业应穿工作服,戴防毒口罩或用2.5%~10%碘处理过的活性炭口罩。工作服应定期更换、清洗除汞并禁止携出车间。班后、饭前要洗手、漱口,严禁在车间内进食、饮水和吸烟。
3.上岗前和在岗期间体检:汞作业工人每年应坚持健康体检,查出汞中毒病人应调离汞作业并进行驱汞治疗。坚持上岗前体检,患有明显肝、肾和胃肠道器质性疾患、口腔疾病、精神神经性疾病等列为职业禁忌证,均不宜从事汞作业。妊娠和哺乳期妇女应暂时脱离汞作业。
请观看中视网视频:汞 隐形杀手(上)和汞 隐形杀手(下)。
央视网视频 > 探索·发现 > 远离毒素(三):贡 隐形杀手(上)
http://tv.cntv.cn/video/C14092/8ddff3a0cbe94c441e5674b2dff07a44
央视网视频 > 远离毒素 > 远离毒素(四):贡 隐形杀手(下)
http://tv.cntv.cn/video/C15773/33437410e73044e31439a090dbfc3c73
(三)砷
【理化特性】 砷(arsenic,As)在地壳中的平均含量可达2mg/kg,有灰、黄和黑三种同素异构体,其中灰色结晶具有金属性,质脆而硬。比重5.73,熔点817°C(2.5Ma),615°C升华。不溶于水,溶于硝酸和王水,具有金属性。在潮湿空气中易氧化成As2O3。元素砷毒性很低,而砷化合物均有毒性,主有As2O3、As2O5、Pb3(AsO4)2、Ca3(AsO3)2,亚砷酸钠等,三价砷化物比五价砷化合物毒性高。
【接触机会】 在自然界中砷主要以硫化物的形式存在,如雄黄(As4S4)、雌黄(As2S3)等,并常以混合物的形式分布于各种金属矿石中。冶炼或焙烧雄黄矿石或其他含砷的金属矿石可接触到其生成的As2O3,处理烟道和矿渣、维修燃烧炉等均可接触As2O3粉尘。含砷农药(如砷酸铅)、防腐剂(如砷化钠)、除锈剂(如亚砷酸钠)、含砷颜料的制造和应用工人的可接触砷;砷合金用做电池栅极、半导体原材料、轴承及强化电缆铅外壳,如高纯砷、砷化镓等。生产中,在有氢和砷同时存在条件下,如有色金属矿石、炉渣中砷遇酸或受潮时,含砷的金属用酸处理时均可产生砷化氢。中医用雄黄、As2O3作为皮肤外用药,治疗痔疮、疥癣等。非职业性接触主要饮用含高浓度砷的井水等,敞灶燃烧含高浓度砷的煤以及砷污染的食品。

雌黄

雄黄
【毒理】
1.吸收 砷化合物可经呼吸道、消化道或皮肤进入体内。职业性中毒主要由呼吸道吸入所致。经呼吸道吸入的大部分是三价砷,多以颗粒物为“载体”被吸入肺部。经消化道的多为三价或五价砷,在消化道内As5+比As3+易吸收,无机砷比有机砷易吸收,且吸收率高,可达95~97%。
2.分布 吸收入血的砷95~97%迅速与Hb的珠蛋白结合,随血液分布到全身各组织和器官,并沉积于肝、肾、肌肉、骨、皮肤、指甲和毛发。As5+与骨组织结合,可在骨中储存数年之久,但其大部分转为As3+,有机砷在体内转变为As3+,As3+易与巯基结合,可长期蓄积于富含巯基的毛发及指甲的角质蛋白中,因此发砷含量可作为监测指标。
3.代谢 五价砷和砷化氢在体内转变为三价砷,吸收的三价砷大部分通过甲基转移酶两次甲基化生成单甲基砷酸(monomethylarsonate)和二甲基砷酸(dimethylarsinic acid)从尿中排出,少量砷可经皮肤、毛发、指甲、粪便、汗腺、乳腺及肺排出,砷可通过胎盘屏障。砷在体内半衰期约10h。
4.毒作用机制 砷是亲硫元素,三价砷极易与巯基(-SH)结合,从而引起含巯基的酶(细胞色素氧化酶、单胺氧化酶、葡萄糖氧化酶、丙氨酸转氨酶等)、辅酶和蛋白质生物活性及其功能改变,尤其是三价甲基砷化物毒性最强,这是砷中毒重要机制。砷与酶作用有单巯基反应和双巯基反应两种方式。前者主要形成As-S复合物,加入过量单巯基供体如GSH即可恢复酶活性;后者是砷与酶或蛋白中的两个巯基反应,形成更稳定的环状化合物,只有双巯基供体如二巯基丙醇才能破坏环状结构,将巯基游离,恢复酶活性。砷进入血液循环以后,可直接损害毛细血管,引起其通透性改变。砷化氢为剧毒类,是强烈溶血性毒物,失去了对RBC膜保护作用,导致RBC溶血。毒性作用主要表现为大量溶血引起一系列变化。
【临床表现】
1.急性中毒(Acute poisoning)
(1)吸入砷化物 工业上因设备事故或违反操作规程大量吸入砷化合物所致急性中毒,主要表现为呼吸道症状及头痛、头晕、全身衰弱,甚至烦躁不安、痉挛和昏迷,消化道症状出现较晚。重者多因呼吸困难和血管中枢麻痹而死亡。
(2)口服砷化物中毒 主要表现为恶心、呕吐、腹痛及血样腹泻,寒战、皮肤湿冷、痉挛等症状。严重者极度衰弱,脱水,少尿、尿闭和循环衰竭,伴神经系统症状,兴奋、躁狂、谵妄、昏迷、惊厥,可因呼吸和血管中枢麻痹而死亡。急性中毒恢复后可留有迟发性末梢神经炎。
(3)砷化氢急性中毒 可在吸入数小时至十余小时内发病,出现急性溶血引发的症状和体征,腹痛、黄疸和少尿三联征是砷化氢中毒的典型表现。尿中可见大量Hb、血球及管型尿,伴有头痛、恶心、腹痛、腰痛、胸部压迫感、皮肤青铜色、肝脾肿大等症状,严重者可导致急性肾衰。
2.慢性中毒(Chronic poisoning)
职业性主要由呼吸道吸入所致,主要是皮肤黏膜病变和多发性神经炎。①皮肤改变可主要表现为脱色素和色素沉着加深(腹部花肚皮):以身体非暴露部位如躯干臀部、大腿上部多见,呈雨点状或广泛的花斑状。掌跖部出现点状或疣状角化:典型的在手掌的尺侧外缘、手指的根部分布许多小的、角样或谷粒状角化隆起,俗称“砒疔”或“砷疔”,通常直径为0.4-25px,也可联合成较大的疣状物或坏死,继发感染,形成经久不愈的溃疡。饮水型砷中毒患者,皮肤改变更为明显,表现为扩大的角化斑块或溃疡(手掌和足底较明显)。


皮肤角化症 角化斑块和溃疡


疣状角化 皮肤溃烂
②慢性中毒可发展为Bowen病、基底细胞癌和鳞状细胞癌。
③砷诱导的末梢神经改变主要表现为感觉异常和麻木,严重者累及运动神经,伴有运动和反射减弱。
④呼吸道粘膜受砷化物刺激可引起鼻衄、嗅觉减退、喉痛、咳嗽、咳痰、喉炎和支气管炎等。
⑤砷是确认的人类致癌物,职业暴露主要致肺癌和皮肤癌,有报道与白血病、淋巴瘤及肝癌等有关。
【诊断】
依据《职业性砷中毒诊断》(GBZ83-2013)进行诊断:
1.诊断原则
(1)职业性急性砷中毒:短时间接触大量砷及其化合物的职业史,出现以呼吸、消化和神经系统损害为主的临床表现,结合尿砷等实验室检查结果,参考现场职业卫生调查综合分析,排除其他类似疾病,方可诊断。
(2)职业性慢性砷中毒:根据长期接触砷及其化合物的职业史,出现皮肤、肝脏和神经系统损害为主的临床表现,参考尿砷和发砷等实验室检查结果,参考现场职业卫生调查综合分析,排除其他类似疾病,方可诊断。
2.接触反应 短时间接触大量砷及其化合物后出现一过性头昏、头痛、乏力或伴有咳嗽、胸闷、眼结膜充血等黏膜刺激症状,经24h~72h观察,上述症状消失或明显减轻。
3.诊断
(1)急性中毒:接触反应的症状加重,并具备下列一项者:急性气管-支气管炎、支气管肺炎(GBZ73);恶心、呕吐、腹痛、腹泻等急性胃肠炎表现;头晕、头痛、乏力、失眠、烦躁不安等症状。
(2)慢性中毒
①轻度中毒 长期接触砷及其化合物的后出现头晕、头痛、乏力、消化不良、消瘦、肝区不适等症状,尿砷和发砷超过当地正常参考值,并具有下列情况之一者:
a)手、脚掌跖部位皮肤角化过度,疣状增生,或躯干部及四肢皮肤出现弥漫的黑色或棕褐色的色素沉着,可同时伴有色素缺失斑;
b)慢性轻度中毒性肝病(见GBZ59);
c)慢性轻度中毒性周围神经病(见GBZ247)。
②中度中毒 轻度中毒症状加重并具有下列情况之一者:
a)全身泛发性皮肤角化过度、疣状增生;或皮肤角化物、脱落形成溃疡长期不愈合;
b)慢性中度中毒性肝病(见GBZ59);
c)慢性中度中毒性周围神经病(见GBZ247)。
③重度中毒:中度中毒的症状加重,并具有下列表现之一者:
a)肝硬化;b)慢性重度中毒性周围神经病(见GBZ247)c)皮肤癌(见GBZ97)。
4.处理原则
(1)治疗原则:
①急性中毒:立即脱离现场,皮肤或眼受污染者,立即用水用清水彻底冲洗,迟早给予巯基络合剂如二巯基丙磺酸等驱砷治疗和对症支持治疗,较重者可酌情使用糖皮质激素治疗。
经口中毒者应迅速催吐、洗胃,洗胃后应投予Fe(OH)2或蛋白水、活性炭至呕吐为止并导泻。一经确诊,应使用巯基络合剂,首选二巯基丙磺酸钠,5mg/kg/次,肌注,第一日1次/6~8h,第二日1次/8~12h,以后每日1~2次,5~7日为一疗程,直至尿砷<50mg/d。
砷化氢中毒,应密切监视血细胞变化和肾功能,要碱化尿液。碱性尿可减少Hb在肾小管沉积和引起肾损伤。血浆游离Hb>150mg/L时或少尿是换血的指征。如果发生急性肾衰,应进行血液透析。
②慢性中毒:可及时脱离砷及其化合物接触,给予巯基络合剂如二巯基丙磺酸钠等驱砷治疗,皮肤改变和多发性神经炎按一般对症处理。此外可辅以保肝、抗氧化剂等对症支持疗法,职业性慢性砷中毒者需调离砷作业。
(2)其他处理:
①急性中毒:经治疗恢复后可继续工作。
②慢性中毒:慢性中毒者应调离砷作业。
③其他:需劳动能力鉴定,按GB/T16180处理。
【预防】 在采矿、冶炼及农药制造过程中,生产设备应采取密闭、通风等技术措施,减少工人对含砷粉尘的接触。在维修设备和应用砷化合物过程中,要加强个人防护。医学监护应注重皮肤、呼吸道以及肝、肾、血液和神经系统功能改变。尿砷监测有助于对工业卫生设施效果的评价。
(四)镉
【理化特性】 镉(Cadmium,Cd)是一种微带蓝色的银白色金属,质软,耐磨,延展性较好,原子量112.41,熔点320.9℃,沸点765℃,固体密度8.65,呈明显碱性,易溶于硝酸,但难溶于盐酸和硫酸。常见的镉化合物有氧化镉(CdO)、硫化镉(CdS)、硫酸镉(CdSO4)和氯化镉(CdCl2)等。
【接触机会】 单纯镉矿少见,主要和锌、铅及铜矿共生。镉及其化合物主要用于电镀,以及工业颜料、塑料稳定剂、镍镉电池、光电池及半导体元件制造等;镉合金用于制造高速轴承、焊料、珠宝等。从事上述职业(包括金属开采与冶炼、电镀及镉的工业应用等)均可接触镉及其化合物。
非职业接触包括:吸入镉污染的空气(如金属矿开采与金属炼厂附近),食用含镉废水灌溉生产的粮食、蔬菜,经常食用镀镉器皿贮放的酸性食物或饮料等。吸烟是慢性接触镉的另一途径。
【毒理】
1.吸收(Absorption) 经呼吸道和消化道进入人体。经呼吸道吸入的镉烟尘,因粒子的大小和化学组成不同,约10~40%经肺吸收。消化道吸收一般低于10%,当人体缺乏铁、钙和蛋白质等时,镉吸收增加可高达20%。
2.分布(Distribution) 吸收入血循环的镉大部分与红细胞结合(主要与血红蛋白结合),亦可与金属硫蛋白结合,后者是一种可诱导的低分子蛋白。血浆中的镉主与血浆蛋白结合。
3.排泄(Excretion) 镉蓄积性强,体内生物半减期长达8~35年,主要蓄积于肾脏和肝脏,肾镉含量约占体内总含量的1/3,而肾皮质镉含量约占全肾的1/3。镉主要通过肾脏随尿液缓慢排出。
4.毒性及中毒机制 镉及其化合物毒性因其品种不同而异,其急性毒性多属低毒至中等毒性类。如:小鼠经口LD50值(mg/Kg):氧化镉72,硫酸镉88,氯化镉150,硫化镉1160。急性吸入毒性比经口摄入毒性大数十倍,死因主要是肺炎和肺水肿,有时可伴有肝、肾等其它脏器损害。
镉具有明显的慢性毒性,可致机体多系统、多器官损害,当前仍然是损害人类健康的重要环境毒物之一。大鼠吸入镉烟尘15~20mg/m3,2h/d,历时1~6个月,见血红蛋白和红细胞数下降、白细胞计数增多、血红蛋白下降,出现肺间质性肺炎和局灶性肺气肿。镉可致肾脏的慢性损害,主要发生在近曲小管,呈现具特征性的肾小管重吸收功能障碍,肾小球亦可受累。生殖系统损害也十分明显,小鼠皮下注射氯化镉或乳酸镉,可引起精原上皮细胞、间质的破坏、精子数量减少,活动能力下降。30~60天氯化镉亚慢性染毒结果显示,大鼠或小鼠均出现了动情周期明显异常、卵泡细胞生长发育出现障碍。镉还被认为是高度可疑的环境内分泌干扰物,低剂量镉可能具有雌激素样作用,而剂量较大时可致雄性实验动物血液睾酮水平下降、雌性动物雌激素、黄体生成素(LH)水平异常等,可抑制卵巢颗粒细胞雌、孕激素的合成。动物实验表明镉有致畸作用,并可致骨质疏松等。
镉可诱导肝脏合成金属硫蛋白,并经血液转移至肾脏,被肾小管吸收蓄积于肾。镉金属硫蛋白的形成可能与解毒和保护细胞免受损伤有关。
镉中毒机制目前尚不十分清楚。有研究表明:镉与巯基、羟基等配基的结合能力大于锌,因此可干扰以锌为辅基的多种酶类活性(主要是置换酶中的锌),导致机体机能障碍。例如:镉中毒时,可见到肾小管细胞中含锌的亮氨酰基氨肽酶(leucylaminopeptidase)活性受抑制,致使蛋白质分解和重吸收减少,出现肾小管性低分子蛋白尿。实验还显示,锌和硒可防止或抑制镉的某些毒作用。镉对下丘脑-垂体-性腺轴调节功能的影响其生殖内分泌干扰作用的重要机制之一。
【临床表现】
(1)急性中毒:急性吸入高浓度镉烟数小时后,出现咽喉痛、头痛、肌肉酸痛、恶心、口内有金属味,继而发热、咳嗽、呼吸困难、胸部压迫感、胸骨后疼痛等。严重者可发展为突发性化学性肺炎,伴有肺水肿和肝、肾损害,可因呼吸衰竭死亡。
(2)慢性中毒:低浓度长期接触可发生慢性中毒。最常见的是肾损害。肾小球滤过功能多为正常,而肾小管重吸收功能下降,以尿中低分子蛋白(分子量30000以下)增加为特征,如β2-微球蛋白等。继续接触,可发展成Fanconi综合征,伴有氨基酸尿、糖尿、高钙和高磷酸盐尿。肾小管功能障碍可引起肾石症和骨软化症。也可引起呼吸系统损伤和肺气肿。
慢性接触镉者可出现嗅觉减退及贫血(主因红细胞脆性增加),可致肺部损害,如肺气肿等。流行病学调查表明,接触镉工人中肺癌及前列腺癌发病率增高。含镉工业废水污染环境(如饮用水、稻谷的镉污染),因饮食而致镉摄入量增加后可致骨痛病,日本发生的“痛痛病事件”即属此类。镉污染区育龄妇女生殖状况调查结果显示,其月经异常发生率、流产发生率均高于对照人群
【诊断】 急性中毒时,根据职业接触史和临床表现不难诊断,而慢性镉中毒的诊断较为困难。慢性中毒所致低分子蛋白尿是早期诊断指征之一。实验室检查包括生物材料中镉含量测定、尿蛋白(特别是低分子蛋白)测定和肾功能检查有助确定诊断。血镉水平与近期暴露有关,对监测慢性接触意义不大。尿镉一般不超过0.01mg/gCr,尿中低分子蛋白测定(如尿β2-微球蛋白含量),常是较敏感的指标。我国现行诊断标准:职业性镉中毒诊断标准(GBZ 17-2002)。
职业性镉中毒的诊断(GBZ17-2015)于2015年12月15日发布,2016年5月1日实施。
1.诊断原则 短时间高浓度或长期密切的职业接触史,以呼吸系统或肾脏损害为主的临床表现和尿镉测定,参考现场劳动卫生调查资料,经鉴别诊断排除其它类似疾病后可作出急性或慢性镉中毒诊断。
2.观察对象 尿镉测定连续两次在5mmol/mol肌酐 (5mg/g肌酐)以上,尚无慢性镉中毒临床表现。
3.诊断分级标准
(1)慢性镉中毒
①慢性轻度中毒 除尿镉增高外,可有头晕、乏力、嗅觉障碍腰背及肢体痛等症状,实验室检查发现有以下任何一项改变时,可诊断:
a)尿β2-微球蛋白含量在9.6 mmol/mol肌酐(1000mg/g肌酐)以上;
b)尿视黄醇结合蛋白含量在5.1mol/mol肌酐(1000mg/g肌酐)以上。
②慢性重度中毒 除慢性轻度中毒的表现外,出现慢性肾功能不全可伴有骨质疏松症、骨质软化症。
(2)急性镉中毒
①急性轻度中毒 短时间内吸入高浓度的氧化镉烟尘,在数小时或1天后出现咳嗽、咳痰、胸闷等,两肺呼吸音粗糙,或可有散在的干、湿啰音,肺部X射线表现为肺纹理增多、增粗、延深,符合急性气管-支气管炎或支气管周围炎。
②急性中度中毒 具有下列表现之一者:
a)急性肺炎;b)急性间质性肺水肿。
③急性重度中毒 有下列情况之一者:
a)急性肺泡性肺水肿;b)急性呼吸窘迫综合征(ARDS)。
【处理原则】 急性吸入氧化镉烟者常应入院观察,应注意急性肺损伤,加强对症治疗。早期可短期、小剂量使用肾上腺皮质激素治疗,有利于防止肺水肿。严重者可用EDTA等络合剂治疗,但应严密监视肾功能,因络合剂可增加肾毒性损害。禁用二巯基丙醇。
慢性中毒者,包括肾损伤、肺气肿及骨病等,应脱离进一步接触,加强对症处理,积极治疗。出现生殖系统损害时,应该避免继续接触,积极促进康复。
【预防】
在焊接和切割含镉金属以及产生氧化镉烟的场所,要加强密闭、局部通风和个人防护。开展生物监测和定期体检,尤应注意尿蛋白、尿糖的早期监测。要重视生殖系统周期损害的检测,重视非职业性镉接触的危害。中毒者应及时治疗,防止肾损伤。
(五)锰
【理化特性】 锰(manganese)为浅灰色金属。原子量54.94,比重7.4,熔点1244℃,沸点1962℃。质脆,反应活泼,溶于稀酸。常见的锰化合物有二氧化锰、四氧化三锰、氯化锰、硫酸锰、铬酸锰、高锰酸钾等。
【接触机会】 锰矿石的开采、粉碎、运输、加工和冶炼,制造锰合金。锰化合物用于制造干电池,焊料、氧化剂和催化剂,焊接和风割锰合金以及制造和应用二氧化锰、高锰酸盐和其他锰化合物等。用锰焊条电焊时,可发生锰烟尘。因锰的毒性很小,生理需要量与中毒量的比率约为1:200,故短期摄入锰引起的中毒报道较少,但若长期慢性接触可致中毒。
【毒理】 锰中毒与锰作业时间、锰烟尘浓度、防护措施有密切关系。
(1)吸收 锰主要通过呼吸道和胃肠道吸收,皮肤吸收甚微。锰主要以烟尘形式经呼吸道吸收。
(2)分布 入血的锰与血浆中的β-球蛋白结合为转锰素分布于全身。
小部分进入红细胞,形成锰卟啉,并迅速从血液中转移到富有线粒体的细胞中,以不溶性磷酸盐的形式蓄积于肝、肾、脑及毛发中,且细胞内的锰2/3贮留于线粒体内,后期脑中含锰量甚至可超过肝的存积量,多在豆状核和小脑。
少部分经胃肠道吸收的锰入肝,在血浆铜蓝蛋白作用下将Mn2+氧化成Mn3+,再经铁传递蛋白转运至脑毛细血管脉络丛
(3)毒作用机制 锥体外系神经障碍,产生帕金森综合征的临床表现。
①线粒体功能失调 锰能特异性地蓄积在线粒体中,在有线粒体的神经细胞和神经突触中,抑制线粒体的ATP酶和溶酶体中的酸性磷酸酶活力,从而影响神经突触的传导能力。
②神经递质代谢障碍 锰还引起多巴胺和5-羟色胺含量减少。锰又是一种拟胆碱样物质,可影响ChE合成,使Ach蓄积,此与锰中毒时出现震颤麻痹有关。
(4)排泄 锰大多经胆囊分泌进入肝肠循环,主要随粪便缓慢排出,尿中排出少量,唾液、乳汁、汗腺排出微量。
【临床表现】
(1)急性中毒 大量吸入新生的氧化锰烟雾后,少数人可发生锰所致“金属烟热”。生产中吸入高浓度的无机锰化合物烟尘,除引起轻度呼吸道刺激症状外,一般无急性中毒表现。
(2)慢性中毒:是锰的主要职业危害,多见于锰铁冶炼、电焊条的制造与电焊作业的工人。主要表现为锥体外系神经障碍。
起病缓慢,发病工龄一般5-10年。早期主要表现为类神经症和自主神经功能障碍(嗜睡、精神萎靡、注意力涣散、记忆力减退等)。继而出现锥体外系神经受损症状,四肢肌张力增高,手指明显震颤,腱反射亢进,并有神经情绪改变如激动、多汗、欣快、情绪不稳定。后期出现典型的帕金森综合征:说话含糊不清、面部表情减少、动作笨掘、慌张步态、肌张力呈齿轮样增强、双足沉重感、静止性震颤,并于精神紧张时加重,以及不自哭笑、记忆力显著减退、智能下降、强迫观念和冲动行为等精神症状。体征可见蹲下易于跌倒、闭目难立试验阳性、单足站立不稳、轮替缓慢。
严重:锥体外系障碍恒定而突出,并可出现锥体束神经损害。
锰烟尘可引起肺炎、尘肺,尚可发生结膜炎、鼻炎和皮炎。
【诊断】 急性锰中毒的诊断并不难。慢性锰中毒依据职业性慢性锰中毒诊断标准(GBZ 3-2006)进行。
1.诊断原则:应根据密切的职业接触史和以锥体外系损害为主的临床表现,参考作业环境调查、工作场所空气中锰浓度测定进行综合分析,排除其它类似疾病,方可诊断。
2.观察对象 具有头晕、头痛、易疲乏、睡眠障碍、健忘等类神经症症状以及食欲减退、流涎、多汗、心悸、性欲减退等自主神经功能紊乱的表现,同时可肢体疼痛、下肢无力和沉重感等。
3.分级标准
(1)轻度中毒 除上述症状外,具有下列情况者:
肌张力增高不恒定,手指明显震颤,情绪低落、注意力涣散、对周围事物缺乏兴趣或易激动、多语、欣快感等精神情绪改变。
(2)中度中毒 在轻度中毒基础上出现恒定的四肢肌张力增高,常伴有静止性震颤。
(3)重度中毒 在中度中毒基础上具有下列情况之一者:
a)明显的锥体外系损害全身肌张力明显增高,四肢出现粗大震颤,震颤可累及下颌、颈部和头部;步态明显异常。
b)严重精神障碍 有显著的精神情绪改变,如感情淡漠、反应迟钝、不自主哭笑、强迫观念、冲动行为、智力障碍等。
4.影像诊断:
(1)CT检查:主要表现为脑萎缩及脱髓鞘改变,对锰中毒的临床诊断没有特征意义。
(2)磁共振成像(MRI)检查:锰可选择性地蓄积在大脑苍白球、壳核、中脑黑质及垂体前叶。MRI检查时T1加权信号增强而T2加权未见异常是锰中毒的特征性变化,但这只可反映锰在脑中的蓄积情况,不一定是锰中毒,所以MRI检查对锰中毒具有辅助诊断意义。
【处理原则】
急性口服高锰酸钾中毒应立即用温水洗胃,口服牛奶和氢氧化铝凝胶。锰烟雾引起的“金属烟热”可对症处理。
驱锰治疗,早期可用金属络合剂依地酸钙钠、促排灵或二巯基丁二钠治疗,近年来用对氨基水杨酸钠(PSA-Na)治疗锰中毒,改善病人症状和体征并且副作用小而少,但目前在临床尚未广泛应用。出现震颤性麻痹综合征可用左旋多巴和安坦治疗。
凡诊断为锰中毒者,包括已治愈的病人,不得继续从事锰作业;轻度中毒者治愈后可安排其它工作;重度中毒者需长期休息。
【预防】
预防锰中毒主要是加强通风排毒和个人防护。接触锰作业应采取防尘措施和佩带防毒口罩,焊接作业尽量采用无锰焊条,或用自动电焊代替手工电焊,使用抽风及吸尘装置。禁止在工作场所吸烟和进食。
(六)其他金属与类金属
其他金属:铬(Cr)、镍(Ni)、锌(Zn)、铊(Ti)、钡(Ba)、铍(Be)、钒(V)、锡(Sn)、铝(Al)。
1.铬(chromium,Cr)
(1)理化特性 银灰色、抗腐蚀性强、硬而脆的坚硬金属;比重7.2,熔点1890℃,沸点2482℃;溶于稀盐酸及硫酸。主要有金属铬、三价铬和六价铬三种形式。工业上常用的是六价铬和三价铬化合物。如氧化铬、三氧化铬、铬酸、氯化铬、铬酸钠、铬酸钾、重铬酸钾和重铬酸钠。
(2)接触机会 化工和电镀工人;铬矿开采、冶炼可接触铬尘和铬酸雾;镀铬可接触铬酸雾;油漆、鞣革、橡胶、陶瓷等工业可接触铬酸盐;含铬的木材防腐剂、农药杀霉菌剂、阻冻剂、杀藻类剂,铬酸洗液。
(3)毒理 所有铬的化合物都有毒性;六价铬毒性比三价铬高100倍,六价铬在细胞内被转变成三价铬后,通过和蛋白质及核酸紧密结合发挥毒性作用;铬酸盐可经呼吸道、消化道和皮肤吸收。低浓度致敏,高浓度对皮肤有刺激和腐蚀作用,长期暴露铬盐的粉尘或铬酸雾主要引起皮肤和黏膜损害。
(4)毒作用表现
①急性中毒:接触高浓度铬酸或铬酸盐,可刺激眼、鼻、喉及呼吸道黏膜,引起灼伤、充血、鼻衄等。严重者因肾功能衰竭死亡。

铬中毒
②慢性中毒:病变主要部位在皮肤和鼻子。皮炎表现:片块状红斑、丘疹。典型的皮肤溃疡称铬疮,为不易愈合的侵蚀性溃疡,多发生在手指、手背易擦伤部位,溃疡边缘隆起而坚硬,中间凹陷,上覆黄褐色结痂,外观呈“鸡眼状”,可深达内膜,治愈后留有边界清楚的圆形疤痕。

铬疮
铬鼻病:由六价铬化合物引起以鼻黏膜糜烂、溃疡和鼻中隔穿孔为主的病变。中毒表现:流涕、鼻塞、鼻衄、鼻干燥、鼻灼痛、嗅觉减退等症状,及鼻黏膜充血、糜烂、肿胀、干燥或萎缩等体征,重者鼻中隔软骨部穿孔;另外从事铬化合物生产工人肺癌发病率增高。
(5)诊断标准 职业性接触性皮炎诊断标准(GBZ 20-2002);铬溃疡根据职业性皮肤溃疡诊断标准(GBZ 62-2002);铬鼻病根据职业性铬鼻病诊断标准(GBZ 12-2002);铬酸盐制造业工人肺癌根据职业性肿瘤诊断标准(GBZ 94-2002)进行诊断。
(6)防治要点
预防:加强通风、戴防毒口罩;工人穿工作服并戴橡胶长手套;接触铬工人戒烟。
治疗:鼻黏膜和皮肤溃疡局部可用10%抗坏血酸擦洗,或涂10%复方依地酸二钠钙软膏。鼻中隔穿孔患者,需行鼻中隔修补术。
2.镍(nickel,Ni)
(1)理化特性 银白色、坚韧并带磁性的金属;比重8.9,熔点1453℃,沸点2732℃;溶于硝酸;可形成液态羰基镍(nickelcarbonyl)。工业上常见镍化合物有一氧化镍、三氧化二镍、氢氧化镍、硫酸镍、氯化镍和硝酸镍等。
(2)接触机会 镍矿开采、冶炼,不锈钢生产,铸币、电池、原子能工业应用各种镍合金;羰基镍用于精炼、有机合成,橡胶工业等。
(3)毒理 可溶性镍化合物和羰基镍易经呼吸道吸收并与白蛋白结合,但并不在组织中蓄积,主要经尿排出,半减期约1周。镍易透过胎盘屏障,不溶性镍化合物可蓄积在呼吸道。
(4)毒作用表现
主要毒作用表现:为皮炎和呼吸道损害。皮炎:可溶性镍化合物主要引起接触性皮炎和过敏性湿疹。呼吸道损害:高浓度镍气溶胶可引起鼻炎、鼻窦炎、嗅觉缺失、鼻中隔穿孔,对镍及其化合物高度敏感者,可产生支气管哮喘或肺嗜酸粒细胞浸润症;高浓度羰基镍短期内吸入主要引起急性呼吸系统和神经系统损害;镍精炼:使工人鼻和呼吸道肿瘤发病率增高。

镍化合物主要引起接触性皮炎和过敏性湿疹
(5)诊断 羰基镍中毒根据职业性急性羰基镍中毒诊断标准(GBZ28-2010)诊断;接触性皮炎根据职业性接触性皮炎诊断标准(GBZ 20-2002)进行。
(6)防治要点 镍皮炎可用局部激素疗法并脱离进一步接触,严重过敏者应脱离镍作业;接触羰基镍者可检测尿中镍含量,可用二乙基二硫代甲酸钠驱镍。
3.锌(zincum,Zn)
(1)理化特性 银白色金属;不溶于水,溶于强酸或碱液;比重7.14,熔点419.4℃,沸点907℃,加热到500℃时可形成直径小于1μm的氧化锌烟尘。
(2)接触机会 锌冶炼、炼铜、焊接镀锌铁等可接触氧化锌烟尘;镀锌和生产锌合金可接触锌化合物;锌白用于颜料,硫酸锌用于人造丝、医药等。
(3)毒理
吸收:氧化锌烟尘可经呼吸道吸收,锌化合物经口摄入只20%~30%经消化道吸收。进入循环的锌与血浆中金属硫蛋白、白蛋白及红细胞结合,广泛分布于组织中,但主要在横纹肌。
排出:吸收的锌主要经胰液、胆汁和汗液排出,仅有20%由肾脏排出。
(4)毒作用表现
急性中毒:过量接触氧化锌烟雾后发生金属烟热(metal fume fever),表现为头痛、口中金属味,接着出现肌肉和关节痛及疲劳、发热、寒战、多汗、咳嗽,8~12h后可出现胸痛,24~48h后症状消失,类似“流感”过程。接触氯化锌可引起严重皮肤及眼灼伤。
慢性皮肤接触:主要引起湿疹性皮炎或皮肤过敏。
(5)诊断 氧化锌所致金属烟热按金属烟热诊断标准(GBZ 48-2002)进行。加强局部通风措施可减少氧化锌烟雾接触。
(6)防治要点 加强局部通风等措施减少氧化锌烟雾接触。金属烟热对症治疗。
4.铊(thallium,Ti)
(1)理化特性 银灰色;比重11.85,熔点303.5℃,沸点1457℃;易溶于硝酸和浓硫酸。
(2)接触机会 铊产生于制造合金及铊化合物的生产过程中;含硫酸铊的杀鼠剂和杀虫剂;溴化铊和碘化铊是制造红外线滤色玻璃的原料;铊的氧化物和硫化物可制光电管;铊汞齐用于制造低温温度计。
(3)毒理 高毒类,铊烟尘、蒸气或可溶性铊盐可通过消化道、皮肤和呼吸道被吸收。体内代谢分布:铊可迅速分布到机体各组织中的细胞内,铊和钾类似,可稳定地和一些酶(如Na+-K+-ATP酶)结合,铊还可和巯基结合干扰细胞内呼吸和蛋白质合成,铊和核黄素结合可能是其神经毒性的原因。
(4)毒作用表现
急性中毒:表现为胃肠道刺激症状,继而出现神经麻痹,精神障碍,甚至肢体瘫痪,肌肉萎缩。脱发是铊中毒的特殊表现(症状),常于急性中毒后1~3周出现,头发呈束脱落,表现为班秃或全秃,严重者体毛全部脱落。
慢性中毒:毛发脱落及皮肤干燥,并伴疲劳和虚弱感,可发生失眠、行为障碍、精神异常,以及内分泌紊乱,包括阳痿和闭经。
(5)诊断
急慢性铊及其化合物中毒根据职业性铊中毒诊断标准GBZ 226-2010诊断。
(6)防治要点 严禁在接触铊的工作场所进食和吸烟,并戴防护口罩或防毒面具、手套,穿防护服;工作后进行淋浴。误服者应催吐,用1%鞣酸或硫酸钠洗胃后用普鲁士蓝。对严重中毒病例,可考虑血液净化和肾上腺糖皮质激素疗法。
5.钡(barium,Ba)
(1)理化特性 银白色金属;熔点725℃,沸点1140℃;金属钡主要用作制造合金。钡能与卤素和氧直接反应;钡与水猛烈反应,生成氢氧化钡和氢;加热下能与氢、硫、氮、碳作用。
(2)接触机会 钡矿开采、冶炼、各种钡化合物的生产和使用。金属钡可作消气剂和制造各种合金。硫酸钡可作白色颜料,医用造影剂,纺织、橡胶、肥皂、水泥、塑料的填充剂;氯化钡用于制造其他钡盐、钢材淬火等;碳酸钡用于陶瓷、搪瓷、玻璃工业。
(3)毒理 除难溶的硫酸钡外,所有钡的化合物都有毒。吸收途径:钡剂可以经过消化道、皮肤、呼吸道吸收。毒作用:钡是一种肌肉毒,钡离子对骨骼肌、平滑肌、心肌等各种肌肉组织产生过度的刺激和兴奋作用。钡中毒时细胞膜上的Na+-K+-ATP酶继续活动,故细胞外液中的钾不断进入细胞,但钾从细胞内流出的孔道被特异地阻断,因而发生低钾血症。
(4)毒作用表现
主要症状:胃肠道刺激症状和低钾症候群。
主要表现:早期钡中毒表现为头晕或头痛,咽干、恶心、轻度腹痛和腹泻等神经及消化系统症状。重者胸闷、心悸、肌无力或瘫痪,甚至呼吸肌麻痹。心电图异常及血清低钾,多伴有严重的心律失常、传导阻滞。
(5)诊断 钡中毒按职业性急性钡中毒诊断标准(GBZ 63-2002)诊断。
(6)防治要点 生产设备密闭化,安装通风除尘设备,佩戴职业病个人防护用品,一旦皮肤污染,立即冲洗。皮肤灼伤者用2%~5%硫酸钠彻底冲洗后再按灼伤常规处理,钡化合物粉尘经呼吸道相消化道进入者,漱口后,口服适量的硫酸钠,补充钾盐。
6.铍(beryllium,Be)
(1)理化特性 钢灰色金属;熔点1283℃,沸点2970℃;微溶于热水,可溶于稀盐酸,稀硫酸和氢氧化钾溶液。
(2)接触机会 铍是原子能工业之宝,火箭、导弹、卫星、航空、宇航、电子以及冶金工业等可暴露铍。
(3)毒理 铍及其化合物为高毒物质;主要以粉尘、烟雾和蒸汽经呼吸道吸入,破损皮肤易吸收引起皮炎或溃疡;难溶的氧化铍主要储存在肺部,可引起肺炎。可溶性的铍化合物主要储存在骨骼、肝脏、肾脏和淋巴结等处,它们可与血浆蛋白作用,生成蛋白复合物,引起脏器或组织的病变。
(4)毒作用表现
急性中毒:表现为化学性支气管炎和肺炎。
慢性铍中毒引起以肺肉芽肿病变为主的全身性疾病,又称铍病。
急性铍病:以急性呼吸道化学性炎症为主。
慢性铍病:以肺部肉芽肿和肺间质纤维化为主。
(5)诊断 铍病根据职业性铍病诊断标准(GBZ 67-2002);铍接触性皮炎根据职业性接触性皮炎诊断标准(GBZ20-2002);铍溃疡根据职业性皮肤溃疡诊断标准(GBZ 62-2002)进行。
(6)防治要点 生产工艺过程密闭化、机械化,尽可能采用湿式作业,避免高温加工。工作时穿戴工作服和鞋帽,工作后淋浴,工作服用机器洗涤。慢性中毒者可用肾上腺皮质激素及依地酸二钠钙治疗。
7.钒(vanadium,V)
(1)理化特性 银白色金属;比重6.1,熔点1919±2℃,沸点3000~3400℃;钒可加大钢的强度、韧性、抗腐蚀能力、耐磨能力、耐高温、抗奇寒的能力等。
(2)接触机会 钒矿石开采、粉碎及包装,催化剂制造、钒合金、特种钢制造,石油及其分馏后的重油中均含有钒;钒钢在汽车、航空、铁路、电子技术、国防工业等多见。
(3)毒理与毒作用表现
毒理:钒能分别以二、三、四、五价与氧结合,形成四种有毒的氧化物。钒进入细胞后具有广泛的生物学效应。
毒作用表现:短时间内吸入高浓度含钒化合物的粉尘或烟雾引起急性钒中毒,以眼和呼吸道黏膜刺激症状为主。中毒症状一般较轻,重者亦可致心、肾、胃肠及中枢神经系统功能损害。
(5)诊断 钒中毒根据职业性急性钒中毒诊断标准(GBZ 47-2002)进行。
(6)防治要点 作业场所通风除尘,戴过滤式呼吸器。解毒驱钒可用大剂量维生素C,或依地酸二钠钙。口服氯化铵片可加速钒的排泄;有明显皮肤损害者,局部清水冲洗后,涂以肤轻松药膏,同时内服抗过敏药。
8.锡(tin,stannum,Sn)
(1)理化特性 银白色金属;比重5.75,熔点232℃,沸点2270℃;溶于稀酸和强碱。
(2)接触机会 锡矿的开采和冶炼、电路板焊接(焊锡膏)、锡合金、电镀等;有机锡化合物可作合成橡胶的稳定剂。
(3)毒理 锡及其无机化合物大多属微毒或低毒类;有机锡具中高度毒性;无机锡难于经消化道吸收,吸入的锡化合物主要滞留在肺;有机锡化合物可经呼吸道、消化道和皮肤吸收;锡主要经尿和粪排出。
(4)毒作用表现
接触高浓度无机锡尘可引起眼、喉及呼吸道刺激症状,可引起肺部明显X线改变;接触锡烟可致金属烟雾热;有机锡对皮肤有强烈刺激作用,并可经皮肤吸收。某些烃基锡可引起脑白质水肿,表现为剧烈头痛、视力障碍,严重者可致死。
(5)诊断 我国到目前为止还未将锡中毒列为法定职业病,因此也无相应的诊断标准。
(6)防治要点 处理有机锡化合物要严加小心,以免吸入和皮肤接触。皮肤一旦接触有机锡化合物,要用洗涤剂和清水彻底洗净。注意预防和处理脑水肿。
9.铝(aluminum,Al)
(1)理化特性 银白色轻金属,有延性和展性;相对密度2.70,熔点660℃,沸点2327℃;在潮湿空气中能形成一层防止金属腐蚀的氧化膜;易溶于稀硫酸、硝酸、盐酸、氢氧化钠和氢氧化钾溶液,不溶于水。
(2)接触机会 职业性铝接触:主要是铝的冶炼和加工过程中铝烟尘和铝粉尘。
(3)毒理
铝粉尘/烟尘经呼吸道吸入,直接沉积肺内。进入机体的铝以Al(H2O)3+的形式与转铁蛋白、白蛋白或枸橼酸离子结合,随血流分布于肝、脑、肾、骨、肺等组织中,铝可干扰中枢胆碱能系统功能、能量代谢、中枢单胺类系统和氨基酸能系统功能,加强脂质过氧化,影响钙代谢及其相关酶、线粒体和线粒体酶,导致神经细胞凋亡、神经元纤维变性,并对记忆有直接影响。
(4)毒作用表现 职业性吸入铝尘可导致铝尘肺。铝作业工人的定量脑电图异常。铝与某些神经系统疾病如老年性痴呆,帕金森氏综合症等神经退行性疾病有相关关系。
(5)诊断 铝尘肺按《尘肺病诊断标准》(GBZ 70-2009)进行。我国到目前为止还未将铝中毒列为职业病,因此也无相应的诊断标准。
10.磷(phosphorus,P)
(1)理化性质 磷有四种同素异形体,即黄磷(又称白磷)、赤磷(又称红磷)、紫磷、黑磷,其中黄磷毒性最大,其余毒性很小。黄磷为具有蒜臭味的黄白色蜡状固体,不溶于水,易溶于二硫化碳、氯仿和苯。在室温下可自燃,易氧化生成三氧化二磷、五氧化二磷,故常保存于水中。
(2)接触机会 黄磷用于制造磷酸、赤磷、炸药、燃烧弹、化肥、有机磷酸酯等。赤磷用作灭鼠剂(磷化锌)制造等。
(3)毒理
吸收 磷可通过呼吸道、消化道或皮肤接触吸收。黄磷主要以蒸气和粉尘形式经呼吸道进入人体。
分布 主要贮存于肝脏和骨组织中。
排泄 以磷酸盐形式自尿、粪便、汗液缓慢排出。
毒作用机制 在肝脏,磷干扰蛋白和糖代谢并抑制糖原储存,增加脂肪在肝蓄积。黄磷和磷化氢具有高毒性。
(4)临床表现
急性吸入磷蒸气可引起呼吸道刺激和急性肺水肿,严重时出现肝肾损害。长期低浓度接触黄磷主要引起颌骨坏死,开始表现为牙痛,接着感染化脓,呼气有恶臭味。
长期接触有刺激性的磷化合物的工人可发生阻塞性肺疾患和慢性气管炎。
黄磷可致皮肤灼伤并经皮肤吸收引起肝脏损害。
(5)治疗及预防
注意保护皮肤、眼和呼吸道。误服者用0.2%硫酸铜反复洗胃并催吐,禁止导泻和进食牛奶、脂肪类食物,以防加速磷的吸收。颌骨坏死可引流及适当抗生素治疗,严重者需手术和骨移植。皮肤灼伤应对症处理并防治肝脏损害。凡患有严重的口腔疾病、肝肾疾病和血液病、内分泌疾病者不宜从事磷作业。
11.硒(selenium,Se)
(1)理化性质 硒具有金属光泽,不溶于水,溶于硝酸和碱。
(2)接触机会 开采、冶炼。光电管、半导体、玻璃、塑料、橡胶、涂料、医药等工业。
(3)毒理 通过呼吸道、消化道或损伤的皮肤吸收,在肝内被代谢成有机硒化合物,主要经尿排出。
(4)临床表现
急性吸入硒及其化合物烟尘时,可引起严重的呼吸道刺激症状,重者可发生化学性肺水肿,并引起神经、肝、肾损害。氧化硒可引起严重皮肤灼伤。
慢性接触时可引起疲劳、衰弱、胃肠道症状、接触性皮炎及毛发和指甲脱落等。
(5)治疗及预防 硒接触者呼气中如有大蒜味,则表明过度吸收,可适量口服维生素C。禁用络合剂以免引起肾损伤。皮肤烧伤用10%硫代硫酸钠水溶液冲洗,并用10%硫代硫酸钠软膏涂抹。
12.硼(boron,B)
(1)理化性质 硼为黑褐色粉末或晶体状,化学性能稳定。常见的化合物是硼酸和硼砂。
(2)接触机会 硼及其化合物广泛用于合金钢、玻璃、火箭推进剂、汽油添加剂、半导体、核反应堆、太阳能电池、医药等工业领域。
(3)毒理 硼化合物可经呼吸道及消化道吸收,硼酸可经皮肤吸收。过量吸收的硼可在脑、肝、肾、脂肪组织及骨骼中蓄积,以骨骼最多。硼主要经肾脏排出。
(4)临床表现
高浓度氧化硼、硼砂、硼酸主要引起呼吸道、眼和皮肤刺激症状。过度吸收可引起中枢神经系统抑制,胃肠道不适,皮肤脱屑。
慢性接触主要引起脱发。硼烷有剧毒,可致中毒性脑病,长期接触可引起肝、肾损害。
二硼烷类似光气可直接损害呼吸道和肺。
(5)治疗及预防 硼烷中毒主要对症治疗,皮肤污染立即用1%~5%三乙醇胺清洗。硼作业时要注意保护皮肤,避免接触高浓度或有刺激性的硼化合物;


